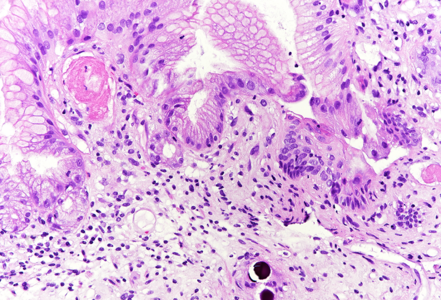
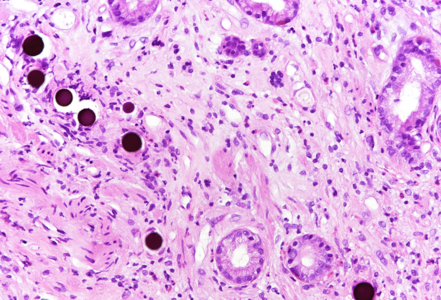

-
Die Universität
- Herzlich willkommen
- Das sind wir
- Medien & PR
-
Studium
- Allgemein
- Studienangebot
- Campusleben
-
Forschung
- Profil
- Infrastruktur
- Kooperationen
- Services
-
Karriere
- Arbeitgeberin Med Uni Graz
- Potenziale
- Arbeitsumfeld
- Offene Stellen
-
Diagnostik
- Patient*innen
- Zuweiser*innen
- Gesundheitsthemen
- Gesundheitsinfrastruktur
Case of the Month
June 2024
A patient with intrahepatic cholangiocarcinoma and gastritis.
Diagnosis
Selective Internal Radiation Therapy (SIRT)-Induced Gastric Injury.
Comment
A 55-year-old patient with established diagnosis of intrahepatic cholangiocarcinoma underwent multiple TACE and SIRT procedures as a palliative care treatment. During the period of receiving the treatments, he suffered from abdominal pain mainly located in the epigastric region and loss of appetite. Oesophagogastroduodenoscopy showed multiple ulcers in stomach and transpyloric region, Forest III, and bulbitis in the duodenum. Biopsies were taken according to the protocol.
Histologically, in the duodenal bulb and all gastric biopsies was visible a blueish spherical foreign material in the stroma, inside small blood vessels, which corresponded to the given chemoembolization medium – yttrium-90 microspheres. Surface mucosa of all samples showed reactive and inflammatory changes with atrophic areas (Panels A-D).
Selective internal radiation therapy (SIRT) is increasingly used for the treatment in non-resectable primary or secondary liver malignancies by injecting intra-arterially radioactive yttrium-90 microspheres. However, due to rich vascularisation of the liver and surrounding organs, migration of microspheres is possible, leading to complications. The most common complications are involving GI tract – gastritis, gastrointestinal ulcers, cholecystitis and liver disease, and non-GI - radiation pneumonitis. That is why awareness of these complications and multidisciplinary approach are necessary for patient’s overall well-being. The pathophysiological mechanism behind gastric injury is not fully understood, but seems to be due to chronic and persistent ischemic injury to the mucosa of the stomach, leading to ulceration and inflammation in the viable mucosa. Please note that reactive cytological and nuclear changes may be marked, thereby mimicking dysplasia (a dangerous caveat).
For further reading
- Ogawa F, Mino-Kenudson M, Shimizu M et al.: Gastroduodenitis associated with yttrium 90-microsphere selective internal radiation: an iatrogenic complication in need of recognition. Arch Pathol Lab Med. 2008 Nov;132(11):1734-8.
- Sun B, Lapetino SR, Diffalha SAL et al.: Microvascular injury in persistent gastric ulcers after yttrium-90 microsphere radioembolization for liver malignancies. Hum Pathol. 2016 Apr:50:11-4.
- Sangro B, Martinez-Urbistondo D, Bester L et al: Prevention and treatment of complications of selective internal radiation therapy: Expert guidance and systematic review. Hepatology. 2017 Sep;66(3):969-982.
- Voruganti IS, Godwin JL, Adrain A, Feller E: A Woman with Black Beads in Her Stomach: Severe Gastric Ulceration Caused by Yttrium-90 Radioembolization. Case Rep Med. 2018 Apr 15:2018:1413724.
Presented by
Dr. Sara Hrg, Zagreb, Croatia, Dr. Cord Langner, Graz, Austria.